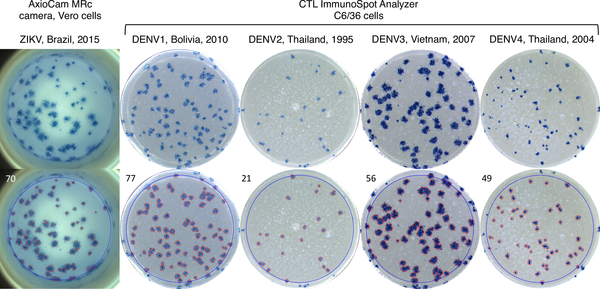

ImmunoSpot® 細胞免疫斑點分析儀
全自動細胞免疫反應檢測平台
為美國Cellular Technology Limited (CTL) 專門量身訂做,提供全面性的 ELISPOT 技術解決方案。
🔬 ImmunoSpot® 核心技術特色與系統功能
⚡ InteliCount™ 智能計數算法
基於25年科學驗證的深度機器學習物體識別技術,20秒內完成96孔ELISPOT板客觀計數分析,解決ELISPOT計數標準化挑戰
💡 CTL Studio™ 模組化軟體平台
如樂高積木般的模組化框架,包含ELISPOT、BioSpot™、ODense™/ELISA、TVA和Reagent Tracker等多功能分析套件
🎯 高精度變焦影像系統
支援16-bit高解析度RAW影像和HDR浮點影像,變焦鏡頭可達顯微鏡級別的單細胞成像和高內容分析
🌈 多色彩檢測技術
支援單色、雙色酵素ELISPOT和多達12色螢光FluoroSpot分析,精確計數細胞激素共表達和功能性T細胞
🔬 多功能檢測平台
除ELISPOT/FluoroSpot外,支援細胞計數、細胞毒性、血清中和、病毒斑點、菌落計數和ELISA檢測
🛡️ ExpressQualify™ 品質驗證
自動掃描條碼參考板驗證儀器性能符合原廠規格,提供完整的品質控制和追溯功能
📏 多板格式支援
支援6孔至1536孔板和Terasaki板等多種格式的全自動讀取,適應不同實驗需求
📈 21 CFR Part 11 法規合規
完整使用者認證、稽核軌跡和數據安全功能,適用於監管環境和BSL 3/4實驗室
⚙️ 一鍵式操作
「一鍵式」InteliCount™算法無需設定計數參數即可獲得客觀一致的結果,確保不同使用者和儀器間的標準化
📊 高內容分析
提供斑點體積測量、尺寸分布、形態學分析等詳細資訊,支援細胞產能和親和力分布研究
🚀 ImmunoSpot® 技術突破
ImmunoSpot®是全球最成功的ELISPOT/FluoroSpot分析儀,由CTL超過25年的領先科學專業知識開發。系統採用專利的InteliCount™技術,將深度機器學習輔助的物體識別技術融入其中,能在20秒內完成96孔ELISPOT板的客觀計數分析。CTL Studio™框架提供模組化軟體套件,包含ELISPOT、BioSpot™、ODense™/ELISA和CTL Reagent Tracker等多種應用,是免疫監測領域的金標準設備。
🔧 ImmunoSpot® S6系列機型比較
| 機型特色 | S6 Entry M2 | S6 FluoroCore M2 | S6 Flex M2 | S6 Ultra M2 | S6 Universal M2 | S6 Ultimate M2 |
|---|---|---|---|---|---|---|
| 主要應用 | 基礎ELISPOT檢測 | 單色螢光檢測 | 四色螢光檢測 | 三色螢光檢測 | 五色可升級12色 | 最高階12色檢測 |
| ELISPOT | 單色、雙色酵素 | 單色 | 單色、雙色酵素 | 單色、雙色酵素 | 單色、雙色酵素 | 單色、雙色酵素 |
| FluoroSpot | 無 | 單色 | 四色 | 三色 | 五色(可升級12色) | 十二色 |
| 相機解析度 | 5 Megapixels | 10 Megapixels | 10 Megapixels | 10 Megapixels | 25 Megapixels | 25 Megapixels |
| 光學系統 | 固定變焦、固定對焦 | 固定變焦、手動對焦 | 固定變焦、手動對焦 | 固定變焦、手動對焦 | 電動變焦、電動對焦 | 電動變焦、電動對焦 |
| 支援板格式 | 96, 384, 1536孔板 | 96, 384孔板 | 24/48/96/384/1536孔板 | 24/48/96/384/1584孔板 | 6-1536孔板及Terasaki | 6-1536孔板及Terasaki |
| LED照明 | 96 LED環 | 96 LED環 | 96 LED環 | 96 LED環 | 114 LED環 | 114 LED環 |
| 螢光激發 | 無 | 藍光LED(480nm) | 藍/綠/紫光LED | 藍/綠光LED | 多色LED光源 | 全光譜LED光源 |
| 條碼讀取器 | 無 | 整合式 | 整合式 | 整合式 | 整合式 | 整合式 |
| 其他檢測 | 病毒中和、菌落計數 | 細胞計數、細胞毒性 | 細胞計數、細胞毒性 | 細胞計數、細胞毒性 | 組織學、ELISA分析 | 組織學、ELISA分析 |
| 法規認證 | 21 CFR Part 11 | 21 CFR Part 11 | 21 CFR Part 11 | 21 CFR Part 11 | 21 CFR Part 11 | 21 CFR Part 11 |
| BSL等級 | BSL 3/4支援 | BSL 3/4支援 | BSL 3/4支援 | BSL 3/4支援 | BSL 3/4支援 | BSL 3/4支援 |
| 適用對象 | 入門級使用者 | 基礎螢光檢測 | 中階多色檢測 | 進階三色檢測 | 高階可升級系統 | 頂級全功能系統 |
🧪 ImmunoSpot® 檢測套組與產品生態系統
CTL 提供完整的免疫監測解決方案,包含檢測套組、參考樣本、無血清培養基和品質控制產品。

T Cell ELISPOT Kits
T細胞細胞激素分泌檢測

B Cell ELISPOT Kits
B細胞抗體分泌檢測

FluoroSpot Kits
多色螢光檢測套組

Double Color Kits
雙色酵素ELISPOT檢測
Viral Neutralization
病毒中和檢測套組

Cytotoxicity Assays
細胞毒性檢測套組
📦 完整生態系統
從儀器、試劑、軟體到技術支援的完整解決方案
🎯 科學驗證
所有套組均經過嚴格的科學驗證和品質控制
📊 標準化流程
提供標準操作程序確保實驗結果的重現性
🧪 ePBMC® Reference Samples 參考樣本
CTL提供完整HLA分型和抗原反應特性的冷凍保存PBMC參考樣本,為檢測程序和性能標準化的完美控制品。這些大批量樣本批次已完全定性,可作為標準化檢測程序的理想對照,大幅降低實驗室內和實驗室間變異性,提高數據一致性。
🧪 CTL Serum-free Media 無血清培養基系列
CTL無血清培養基產品專為支援T細胞生長和性能而配製,消除血清固有的變異性。
🎯 低背景干擾
消除血清中免疫抑制或刺激效應的不可預測變異
📈 提升性能
專為T細胞生長和功能優化的培養基配方
✅ 標準化
減少實驗室內和實驗室間變異性
💰 經濟效益
提供經濟實惠的免疫監測解決方案

CTL-Test™ Medium
專用檢測培養基

CTL-Wash™ Medium
細胞清洗培養基

CTL-Cryo™
細胞冷凍保存液

CTL Anti-Aggregate Wash™
抗聚集清洗液
